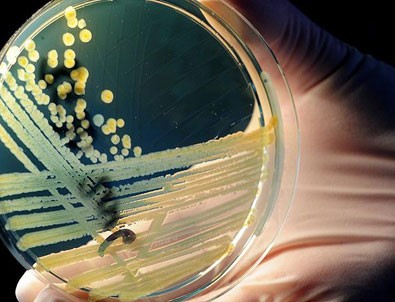
Hastalıklı dokuları aydınlatan nano-bileşke üretildi

Hastalıklı dokuları aydınlatan nano-bileşke üretildi
Bilim adamları insan vücudundaki hastalıklı doku bölgelerini aydınlatarak, kanserli hücrelerin ve diğer doku zararlarının takibine olanak sağlayan polimer nano-bileşke geliştirdi.
Güneş ışığından, kızıl ötesine yakın tayftaki ışıklardan ve hatta cep telefonu ekranlarından enerji alıp depolayabilen YPN'lerin vücuda enjekte edildiğinde zarar gören dokuları uzun süre 'kor gibi' aydınlattığı belirtildi.
Araştırmacılar fareler üzerine yaptıkları deneylerde yöntemin mevcut tıbbi görüntüleme tekniklerine oranla 20 ila 120 kat daha hassas sonuçlar verdiğini saptadı.
Nano-bileşkenin, enjekte edildiği dokudaki hasarlı bölgeyi 6 dakikaya kadar güçlü şekilde aydınlattığı, 6 dakikadan sonra ise parlama şiddetinin yarı ayrıya azalarak devam ettiği görüldü. Bileşkelerin eksi 20 derecede muhafaza edilmesi halinde ise kor halini bir aya kadar muhafaza edebildiği tespit edildi.
Öte yandan ağır metal iyonları içerdiği için hücrelerin zehirlenmesine yol açabilen mevcut tıbbi görüntüleme solüsyonlarının aksine yeni bileşkelerin biyolojik olarak yok olabilen, zehirli olmayan organik parçacıklardan oluştuğu kaydedildi.
Araştırmanın sonuçları 'Nature Biotechnology' dergisinde yayımlandı.
